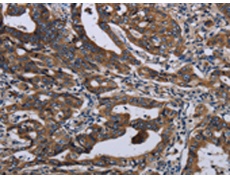
一抗

|
Background: |
This gene encodes a ubiquitously expressed protein that localizes to the cytoplasm. This protein interacts with Bardet-Biedl Syndrome (BBS) proteins and, through its interaction with BBS protein complexes, regulates protein trafficking to the ciliary membrane. Nonsense mutations in this gene cause a form of Bardet-Biedl Syndrome; a ciliopathy characterized in part by polydactyly, obesity, cognitive impairment, hypogonadism, and kidney failure. This gene may also function as a tumor suppressor; possibly by interacting with E-cadherin and the actin cytoskeleton and thereby regulating the transition of epithelial cells to mesenchymal cells. Alternative splicing of this gene results in multiple transcript variants. |
|
Applications: |
ELISA, WB, IHC |
|
Name of antibody: |
LZTFL1 |
|
Immunogen: |
Fusion protein of human LZTFL1 |
|
Full name: |
leucine zipper transcription factor-like 1 |
|
Synonyms: |
BBS17 |
|
SwissProt: |
Q9NQ48 |
|
IHC positive control: |
Human gastric cancer |
|
IHC Recommend dilution: |
50-200 |
|
WB Predicted band size: |
35 kDa |
|
WB Positive control: |
Human transitional cells carcinoma tissue, 293T and A172 cells, human testis tissue and Hela cells |
|
WB Recommended dilution: |
500-2000 |


 購物車
購物車 幫助
幫助
 021-54845833/15800441009
021-54845833/15800441009